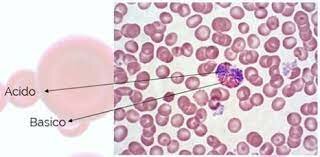
Tinción de Wright

-
 Paul Langerhans utilizó la técnica de tinción de cloruro de oro en 1868 para describir nuevas células de la piel,20 sin embargo, su función queda desconocido para él.
Paul Langerhans utilizó la técnica de tinción de cloruro de oro en 1868 para describir nuevas células de la piel,20 sin embargo, su función queda desconocido para él. -
 El médico y citólogo italiano Camillo Golgi se interesó por el estudio del tejido y de las funciones nerviosas por lo que comenzó a visualizar cortes histológicos teñidos mediante cromato de plata. Con esta tinción pudo evidenciar las formaciones neuronales y las conexiones dendríticas
El médico y citólogo italiano Camillo Golgi se interesó por el estudio del tejido y de las funciones nerviosas por lo que comenzó a visualizar cortes histológicos teñidos mediante cromato de plata. Con esta tinción pudo evidenciar las formaciones neuronales y las conexiones dendríticas -
 El médico danés Hans Christian Gram desarrolló una técnica de tinción en la cual observaba bacterias en tejidos de pulmones de pacientes que morían de neumonía.
El médico danés Hans Christian Gram desarrolló una técnica de tinción en la cual observaba bacterias en tejidos de pulmones de pacientes que morían de neumonía. -
 Es la técnica comúnmente usada en el diagnóstico rutinario de tuberculosis. Es una técnica rápida, fácil y de bajo costo, lo que
Es la técnica comúnmente usada en el diagnóstico rutinario de tuberculosis. Es una técnica rápida, fácil y de bajo costo, lo que
permite que se pueda realizar en casi cualquier laboratorio clínico. Esta tinción permite diferenciar a las bacterias en dos grupos: aquellos que son capaces de resistir la decoloración con alcohol-ácido y aquellos que no lo son. -
 La tinción de azul algodón de lactofenol no es considerada una tinción diferencial, sin embargo, posee características tintoriales que permiten observar cada uno de los componentes fúngicos y apreciar fácilmente las estructuras para una adecuada identificación. El fenol inactiva las enzimas líticas de la célula e impide que ésta se rompa; de igual forma, destruye la flora acompañante e inactiva a la célula,
La tinción de azul algodón de lactofenol no es considerada una tinción diferencial, sin embargo, posee características tintoriales que permiten observar cada uno de los componentes fúngicos y apreciar fácilmente las estructuras para una adecuada identificación. El fenol inactiva las enzimas líticas de la célula e impide que ésta se rompa; de igual forma, destruye la flora acompañante e inactiva a la célula,
quitándole el grado de patogenicidad. -
 Esta tinción proviene de la modificación de la tinción de Ziehl Neelsen, por lo tanto, ambas técnicas se interpretan de la misma forma y tienen como base el mismo fundamento, pero se diferencian en dos aspectos: en el reactivo principal y en que la técnica de Kinyoun no utliza calor. La modificación de Kinyoun a la técnica de Ziehl Neelsen se denomina “método frío”, porque utiliza un detergente tensoactivo como el tergitol, en lugar de tratamiento con calor
Esta tinción proviene de la modificación de la tinción de Ziehl Neelsen, por lo tanto, ambas técnicas se interpretan de la misma forma y tienen como base el mismo fundamento, pero se diferencian en dos aspectos: en el reactivo principal y en que la técnica de Kinyoun no utliza calor. La modificación de Kinyoun a la técnica de Ziehl Neelsen se denomina “método frío”, porque utiliza un detergente tensoactivo como el tergitol, en lugar de tratamiento con calor -
 En la tinción de Schaefer Fulton el colorante primario (verde de Malaquita) se introduce en la espora mediante el calentamiento a emisión de vapores de la preparación. El verde de malaquita es soluble en agua y tiene una baja afinidad por el material celular, por lo que las células vegetativas y las células madre de esporas pueden decolorarse con agua y contra teñirse con safranina (colorante de contraste) por la cual si tienen afinidad.
En la tinción de Schaefer Fulton el colorante primario (verde de Malaquita) se introduce en la espora mediante el calentamiento a emisión de vapores de la preparación. El verde de malaquita es soluble en agua y tiene una baja afinidad por el material celular, por lo que las células vegetativas y las células madre de esporas pueden decolorarse con agua y contra teñirse con safranina (colorante de contraste) por la cual si tienen afinidad. -
 Los gránulos monocromáticos son comunes en Corine bacterias, espirilos y bacilos lácticos y su presencia se utiliza en la identificación de esas bacterias. Estos gránulos tienen una afinidad más fuerte por colorantes básicos que el resto de la célula. Estos aparecen de un color diferente del color original del colorante, fenómeno que se conoce como metacromasia Cuando se tiñen con el colorante de Albert, que contiene verde malaquita, se observan de un color café verdoso oscuro
Los gránulos monocromáticos son comunes en Corine bacterias, espirilos y bacilos lácticos y su presencia se utiliza en la identificación de esas bacterias. Estos gránulos tienen una afinidad más fuerte por colorantes básicos que el resto de la célula. Estos aparecen de un color diferente del color original del colorante, fenómeno que se conoce como metacromasia Cuando se tiñen con el colorante de Albert, que contiene verde malaquita, se observan de un color café verdoso oscuro -
 La tinción negativa fue desarrollada originalmente para microscopia de luz con el fin de rodear y delinear las bacterias no teñidas u otros materiales biológicos. Utilizamos diferentes métodos de tinción negativa para evaluar estructuras individuales, tan pequeñas como
La tinción negativa fue desarrollada originalmente para microscopia de luz con el fin de rodear y delinear las bacterias no teñidas u otros materiales biológicos. Utilizamos diferentes métodos de tinción negativa para evaluar estructuras individuales, tan pequeñas como
las vesículas sinápticas e incluso de gran tamaño, como los microorganismos unicelulares -
Es una técnica que se emplea generalmente para la diferenciación de elementos celulares de la sangre y es clasificada como una tinción policromática, dado que puede teñir compuestos ácidos o básicos presentes en una célula. Desarrollada por el patólogo James Homer Wright a partir de la modificación de la ya existente tinción de Romanowsky.
Es una técnica que se emplea generalmente para la diferenciación de elementos celulares de la sangre y es clasificada como una tinción policromática, dado que puede teñir compuestos ácidos o básicos presentes en una célula. Desarrollada por el patólogo James Homer Wright a partir de la modificación de la ya existente tinción de Romanowsky. -
 Los ácidos micólicos de las paredes celulares de las micobacterias poseen afinidad para los fluorocromos auramina y rodamina. Estos colorantes se fijan a las bacterias, que aparecen de color amarillo o naranja brillante contra un fondo verdoso. El permanganato de potasio, empleado como contraste, evita la fluorescencia inespecífica. Todos los microorganismos ácido-alcohol resistentes, incluyendo los esporozoarios parásitos, se tiñen con estos colorantes.
Los ácidos micólicos de las paredes celulares de las micobacterias poseen afinidad para los fluorocromos auramina y rodamina. Estos colorantes se fijan a las bacterias, que aparecen de color amarillo o naranja brillante contra un fondo verdoso. El permanganato de potasio, empleado como contraste, evita la fluorescencia inespecífica. Todos los microorganismos ácido-alcohol resistentes, incluyendo los esporozoarios parásitos, se tiñen con estos colorantes. -
 M.R.J. Salton explicó el mecanismo de diferenciación de la técnica de Gram.
M.R.J. Salton explicó el mecanismo de diferenciación de la técnica de Gram.
La tinción de Gram diferencia a las bacterias en dos grandes grupos. Se llama bacterias Gram positivas a aquellas que retienen la tinción azul-violeta, y se denomina bacterias Gram negativas a las que se decoloran y después se tiñen con safranina.
Plan projects on a visual timeline
Map milestones, phases, deadlines, and key events in one place so the sequence is easier to see and share. Timetoast is a timeline maker for work, school, research, and stories.
